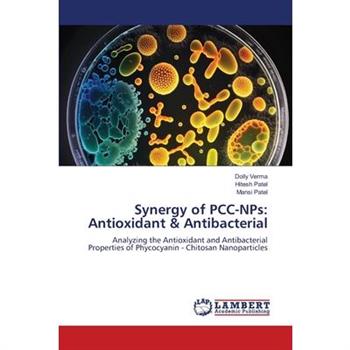
Synergy of PCC-NPs

-
Optical studies and judd ofelt analysis of RE doped Sr2SiO4 NPs
Spectroscopy is the study of interaction of electromagnetic radiation with matter. Optical spectros
-
Synergy of PCC-NPs
In summary, the goal of this work was achieved by successfully separating phycocyanin from Spirulin
-
NPS Multi-level Homes
Ingram 出版This work has been selected by scholars as being culturally important and is part of the knowledge
-
NPS Multi-level Homes
This work has been selected by scholars as being culturally important and is part of the knowledge
-
Unlocking the Value of NPs and PAs
Unlocking the Value of NPs and PAs: Increase Revenue and Create a Healthy and Thriving Practice wit
-
Luminescence studies of CeO2 doped NPs synthesized by chemical route
Cerium oxide (CeO2) was a crystalline material received considerable attention in recent years due
-
Green synthesis of rare earth doped ZrO2 NPs and its applications
The current trend applied in water purification has become one of the main challenges in sustainabl
-
Predicting the Removal Amount of SCN- by TiO2 NPs Using ANN Methods
In this work, the adsorbent method is performed using artificial neural network (ANN) modelin
-
Recent Changes in Drug Abuse Scenario The Novel Psychoactive Substances (NPS) Phenomenon
Ingram 出版In parallel with a decrease/stabilization in the use of internationally controlled drugs, the marke